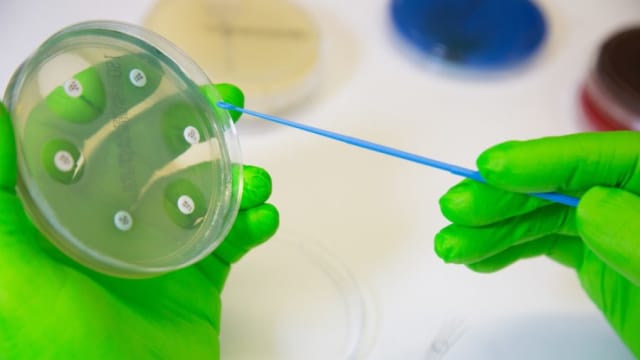
image

Empa-Forschende entwickeln selbsthaftende künstliche Hornhaut
Forschende der Empa und der Universität Zürich haben eine künstliche Hornhaut entwickelt, die künftig Spendergewebe ersetzen könnte.
Loading

Forschende der Empa und der Universität Zürich haben eine künstliche Hornhaut entwickelt, die künftig Spendergewebe ersetzen könnte.

Im Interview erklärt Neurologe Urs Fischer, Chefarzt am Inselspital Bern, was die Ergebnisse der CATALYST-Studie für die klinische Praxis bedeuten – und warum alte Leitlinien überdacht werden sollten.

Zehn Jahre nach der Gründung der Partnerschaft mit dem CHUV und der Uni Lausanne wird das Ludwig-Institut in die Universität integriert. Es soll mehr über Immuntherapie und Tumor-Mikroumgebung geforscht werden.

Thomas Gaisl vom USZ über Präzisionsgewinne, Patientennutzen und technische Grenzen der robotisch-assistierten Bronchoskopie – das Interview.

Besonders in Onkologie, Immunologie und Pharmakologie finden Wissenschaftlerinnen und Wissenschaftler aus der Schweiz weltweit Beachtung.

Solange Peters, Leiterin der medizinischen Onkologie am CHUV, erhält den Paul A. Bunn, Jr. Scientific Award, eine der höchsten internationalen Auszeichnungen für Lungenkrebsforschung.

Thomas Kühnis, Chef der Finanzen, Informatik und Betriebe, verlässt nach neun Jahren die Geschäftsleitung des Kantonsspitals Glarus.

Die Tarifpartner beantragen wie geplant die Genehmigung eines Tarifsystems aus ambulanten Pauschalen und Tardoc.

Wurden beim Verkauf des Spitals Flawil die Vertragspartner getäuscht? Mehrere Kantonsparlamentarier verlangen Antworten von der St.Galler Regierung.